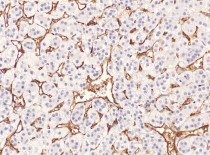

ARG67260
anti-CD105 / Endoglin antibody [SQab30376]
anti-CD105 / Endoglin antibody [SQab30376] for IHC-Formalin-fixed paraffin-embedded sections and Human
Overview
| Product Description | Rabbit Monoclonal antibody [SQab30376] recognizes CD105 / Endoglin. |
|---|---|
| Tested Reactivity | Hu |
| Tested Application | IHC-P |
| Host | Rabbit |
| Clonality | Monoclonal |
| Clone | SQab30376 |
| Isotype | IgG |
| Target Name | CD105 / Endoglin |
| Immunogen | Synthetic peptide. |
| Conjugation | Un-conjugated |
| Alternate Names | ENG; Endoglin; END; HHT1; CD105 Antigen; CD105; ORW1; Osler-Rendu-Weber Syndrome 1; Soluble Endoglin; ORW |
Application Instructions
| Application Suggestion |
|
||||
|---|---|---|---|---|---|
| Application Note | * The dilutions indicate recommended starting dilutions and the optimal dilutions or concentrations should be determined by the scientist. |
Properties
| Form | Liquid |
|---|---|
| Purification | Affinity purification with immunogen. |
| Buffer | PBS, 0.01% Sodium azide, 40% Glycerol and 0.05% BSA. |
| Preservative | 0.01% Sodium azide |
| Stabilizer | 40% Glycerol and 0.05% BSA |
| Storage Instruction | For continuous use, store undiluted antibody at 2-8°C for up to a week. For long-term storage, aliquot and store at -20°C or below. Storage in frost free freezers is not recommended. Avoid repeated freeze/thaw cycles. Suggest spin the vial prior to opening. The antibody solution should be gently mixed before use. |
| Note | For laboratory research only, not for drug, diagnostic or other use. |
Bioinformation
| Database Links | |
|---|---|
| Gene Symbol | ENG |
| Gene Full Name | Endoglin |
| Background | This gene encodes a homodimeric transmembrane protein which is a major glycoprotein of the vascular endothelium. This protein is a component of the transforming growth factor beta receptor complex and it binds to the beta1 and beta3 peptides with high affinity. Mutations in this gene cause hereditary hemorrhagic telangiectasia, also known as Osler-Rendu-Weber syndrome 1, an autosomal dominant multisystemic vascular dysplasia. This gene may also be involved in preeclampsia and several types of cancer. Alternatively spliced transcript variants encoding different isoforms have been found for this gene. [provided by RefSeq, May 2013] |
| Function | Required for GDF2/BMP9 signaling through SMAD1 in endothelial cells and modulates TGFB1 signaling through SMAD3. [Uniprot] |
| Cellular Localization | Cell membrane, Membrane. [Uniprot] |
| Calculated MW | 71 kDa |
| PTM | Disulfide bond, Glycoprotein, Phosphoprotein. [Uniprot] |
Images (1) Click the Picture to Zoom In